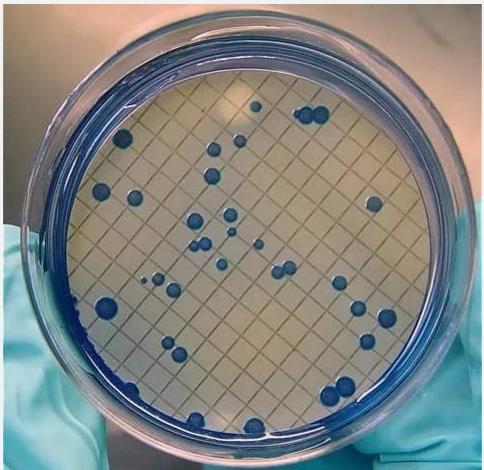

為什么需要如此重視醫療污水和城鎮污水監管工作呢?美國PM Gundy的研究團隊曾在《Survival of Coronaviruses in Water and Wastewater》一文中指出,水體中的有機物和懸浮固體可以吸附冠狀病毒,為病毒的存活提供了保護。同時,從污水流向的我們不難看出,糞便最終排到了污水處理廠,這些可能攜帶新型冠狀病毒的廢水,在污水處理中形成攜帶病毒的氣溶膠,從而形成了氣溶膠傳播的環境,使污水處理人員成為感染風險較大的群體,對阻止疫情傳播有很大的影響。因此,醫療機構、污水處理機構及環境監測部門,都是控制病毒通過污水傳播的關鍵。
目前,為有效防止新型冠狀病毒通過糞便和污水擴散傳播,生態環境部門要求對要接收新型冠狀病毒感染的肺炎患者或疑似患者診療的定點醫療機構(醫院、衛生院等)、相關臨時隔離場所及研究機構,嚴格執行《醫療機構水污染物排放標準》,并參照《醫院污水處理技術指南》、《醫院污水處理工程技術規范》和《新型冠狀病毒污染的醫療污水應急處理技術方案(試行)》等有關要求,對污水和廢棄物進行分類收集和處理,確保穩定達標排放;同時,地方生態環境部門要督促城鎮污水處理廠切實加強消毒工作,結合實際,采取投加消毒劑或臭氧、紫外線消毒等措施,確保出水糞大腸菌群數指標達到《城鎮污水處理廠污染物排放標準》要求。
通過對比以上標準發現,在這些污水處理過程中,糞大腸菌群數是評判污水處理是否合格的關鍵微生物指標。研究表明,污水中糞大腸菌群數量與腸道致病菌數量存在相關關系,當污水中糞大腸菌群數超過1174個/L時,即可在污水中檢出病原菌,因此將糞大腸菌群數作為特征指示性指標對這些微生物進行控制。

根據檢測方法、應用領域和污染情況的不同,各標準中對糞大腸菌群數的限量也不同(表1)。目前,可用于檢測水體中糞大腸菌群數的方法有4種,分別是多管發酵法、膜過濾法和快速熒光檢測法、酶底物法,其中前三種認可度較高,且使用較廣泛。
1、膜過濾法
膜過濾法是目前最常用于水體中糞大腸菌群數檢測的一種標準方法,也是《新型冠狀病毒污染的醫療污水應急處理技術方案(試行)》中的指導方法,可于地表水、地下水、生活污水、工業廢水及醫療污水等樣本的檢測。
該方法使樣品通過孔徑為0.45μm的濾膜過濾,細菌被截留在濾膜上,然后將濾膜置于MFC選擇性培養基上,在特定的溫度(44.5℃)下培養24h,膽鹽三號可抑制革蘭氏陽性菌的生長,糞大腸菌群能生長并發酵乳糖產酸使指示劑變色,通過顏色判斷是否產酸,并通過對呈藍色或藍綠色的菌落進行計數,從而測定樣品中糞大腸菌群濃度。
膜過濾法的關鍵在于樣品前處理,需借助抽濾裝置才可完成,使微生物被截留在無菌濾膜上,并通過物理的方式進行富集,以保證糞大腸菌以菌落形態被檢出。目前,市面上已有較為成熟、有效的的水中膜過濾裝置,可用于水體中微生物前處理操作。

專為水質樣品前處理、富集等操作設計;
結構精巧,配合精密抽濾泵,保證良好的抽濾效果;
不銹鋼材質,可高溫高壓滅菌,避免交叉污染;
直抽直排,防止廢液倒吸。
2、多管發酵法
多管發酵法又稱最大可能數(most probable number,MPN)法或稀釋培養計數法,該方法是用于檢測地表水、地下水、生活污水和工業廢水中糞大腸菌群的測定中糞大腸菌群數的一種標準方法。

該方法是一種基于泊松分布的間接計數法,利用統計學原理,根據一定體積不同稀釋度樣品經培養后產生的目標微生物陽性數,查表估算一定體積樣品中目標微生物存在的數量(即單位體積存在目標微生物的最大可能數)。
采用多管發酵法時,先將樣品加入含乳糖蛋白胨培養基的試管中,37℃初發酵富集培養,大腸菌群在培養基中生長繁殖分解乳糖產酸產氣,產生的酸使溴甲酚紫指示劑由紫色變為黃色,產生的氣體進入倒管(杜氏小管)中,指示產氣。然后再44.5℃復發酵培養,培養基中的膽鹽三號可抑制革蘭氏陽性菌的生長,最后產氣的細菌確定為是糞大腸菌群。最后通過查MPN表,即可得出糞大腸菌群濃度值。
實驗小貼士:
該方法在操作過程中,根據樣品檢出限的不同,可選擇12管法(檢出限為3MPN/L)或15管法(檢出限為3MPN/L)進行實驗,因此需要大量使用試管和液體培養基(每個樣品需準備12或15支試管)。若檢測樣品量較大時,建議可采用培養基分液器來降低工作量。

可用于生理鹽水、液體及半固體培養基自動分裝;
1L溶液分裝到100個MPN法試管中,最快僅需2分鐘;
微電腦系統與精密泵體聯合控制,分裝精度高;
分裝量、分裝速度、分裝時間、停頓時間、分裝次數等參數可自由設定。
采用自動微生物試劑分液器進行實驗用品準備,不僅能實現準確的連續分裝,還可在保證進度的同時,大大降低工作量。
3、快速熒光檢測法
快速熒光檢測法是一種利用ATP熒光原理與微生物特性相結合的快速檢測方法,雖然該方法暫未被納入國家標準中,但由于其操作方便,檢測與培養時間短(僅為膜過濾法、多管發酵法的1/3),目前被很多大型企業作為內部微生物自檢的一種重要手段。通過與對應的采樣、增菌拭子配合使用,可快速檢測水體中糞大腸菌群數量。


快速熒光檢測法是在熒光素酶(lueiferase)和Mg2+的作用下,熒光素(lueiferin)與ATP發生腺苷酰化反應后被活化,活化的熒光素與熒光素酶相結合,形成了熒光素-AMP復合體焦磷酸(PPi)。該復合物在氧化作用下,產生熒光信號。通過ATP檢測液檢測微生物ATP的發光量,達到檢測細菌的目的。該方法現已獲得AOAC研究機構的檢測方法性能擔保認證。
目前,杭州大微已開發了DW-ES800型微生物實時檢測系統,該系統基于ATP熒光快速檢測法,采用雙模塊設計,實現對水體中糞大腸菌群、大腸菌群、大腸桿菌、細菌總數等多種微生物的檢測和計數。

耗時短:培養時間短(定性8小時,定量1~8小時),檢測時間僅需15秒
范圍廣:細菌總數、大腸桿菌、總大腸菌群、糞大腸菌群等多種微生物
效率高:雙培養通道,可同時培養不同溫度微生物
易操作:五步即可完成(增菌拭子采樣→培養→轉移→檢測拭子激活→檢測)
可將RLU值轉換為CFU值
4、酶底物法
酶底物法是檢測水體中大腸菌群、糞大腸菌群和大腸埃希氏菌的一種標準方法。該方法是利用在特定溫度下培養特定的時間,總大腸菌群、糞大腸菌群、大腸埃希氏菌能產生特定的β-半乳糖苷酶將選擇性培養基中的無色底物鄰硝基苯-β-D-吡喃半乳糖苷(ONPG)分解為鄰硝基酚(ONP),呈黃色反應;且大腸埃希氏菌同時又能產生β-葡萄糖醛酸酶將選擇性培養基中的4-甲基傘形酮-β-D-葡萄糖醛酸苷(MUG)分解為4-甲基傘形酮,在紫外燈照射下呈熒光反應。統計陽性反應出現數量,查MPN表,再除以接種樣品的稀釋度。計算相應水樣中總大腸菌群、糞大腸菌群、大腸埃希氏菌的濃度值。由于操作起來較為繁瑣,工作量巨大,故在日常檢測中很少被使用。








當前所在頁面:















